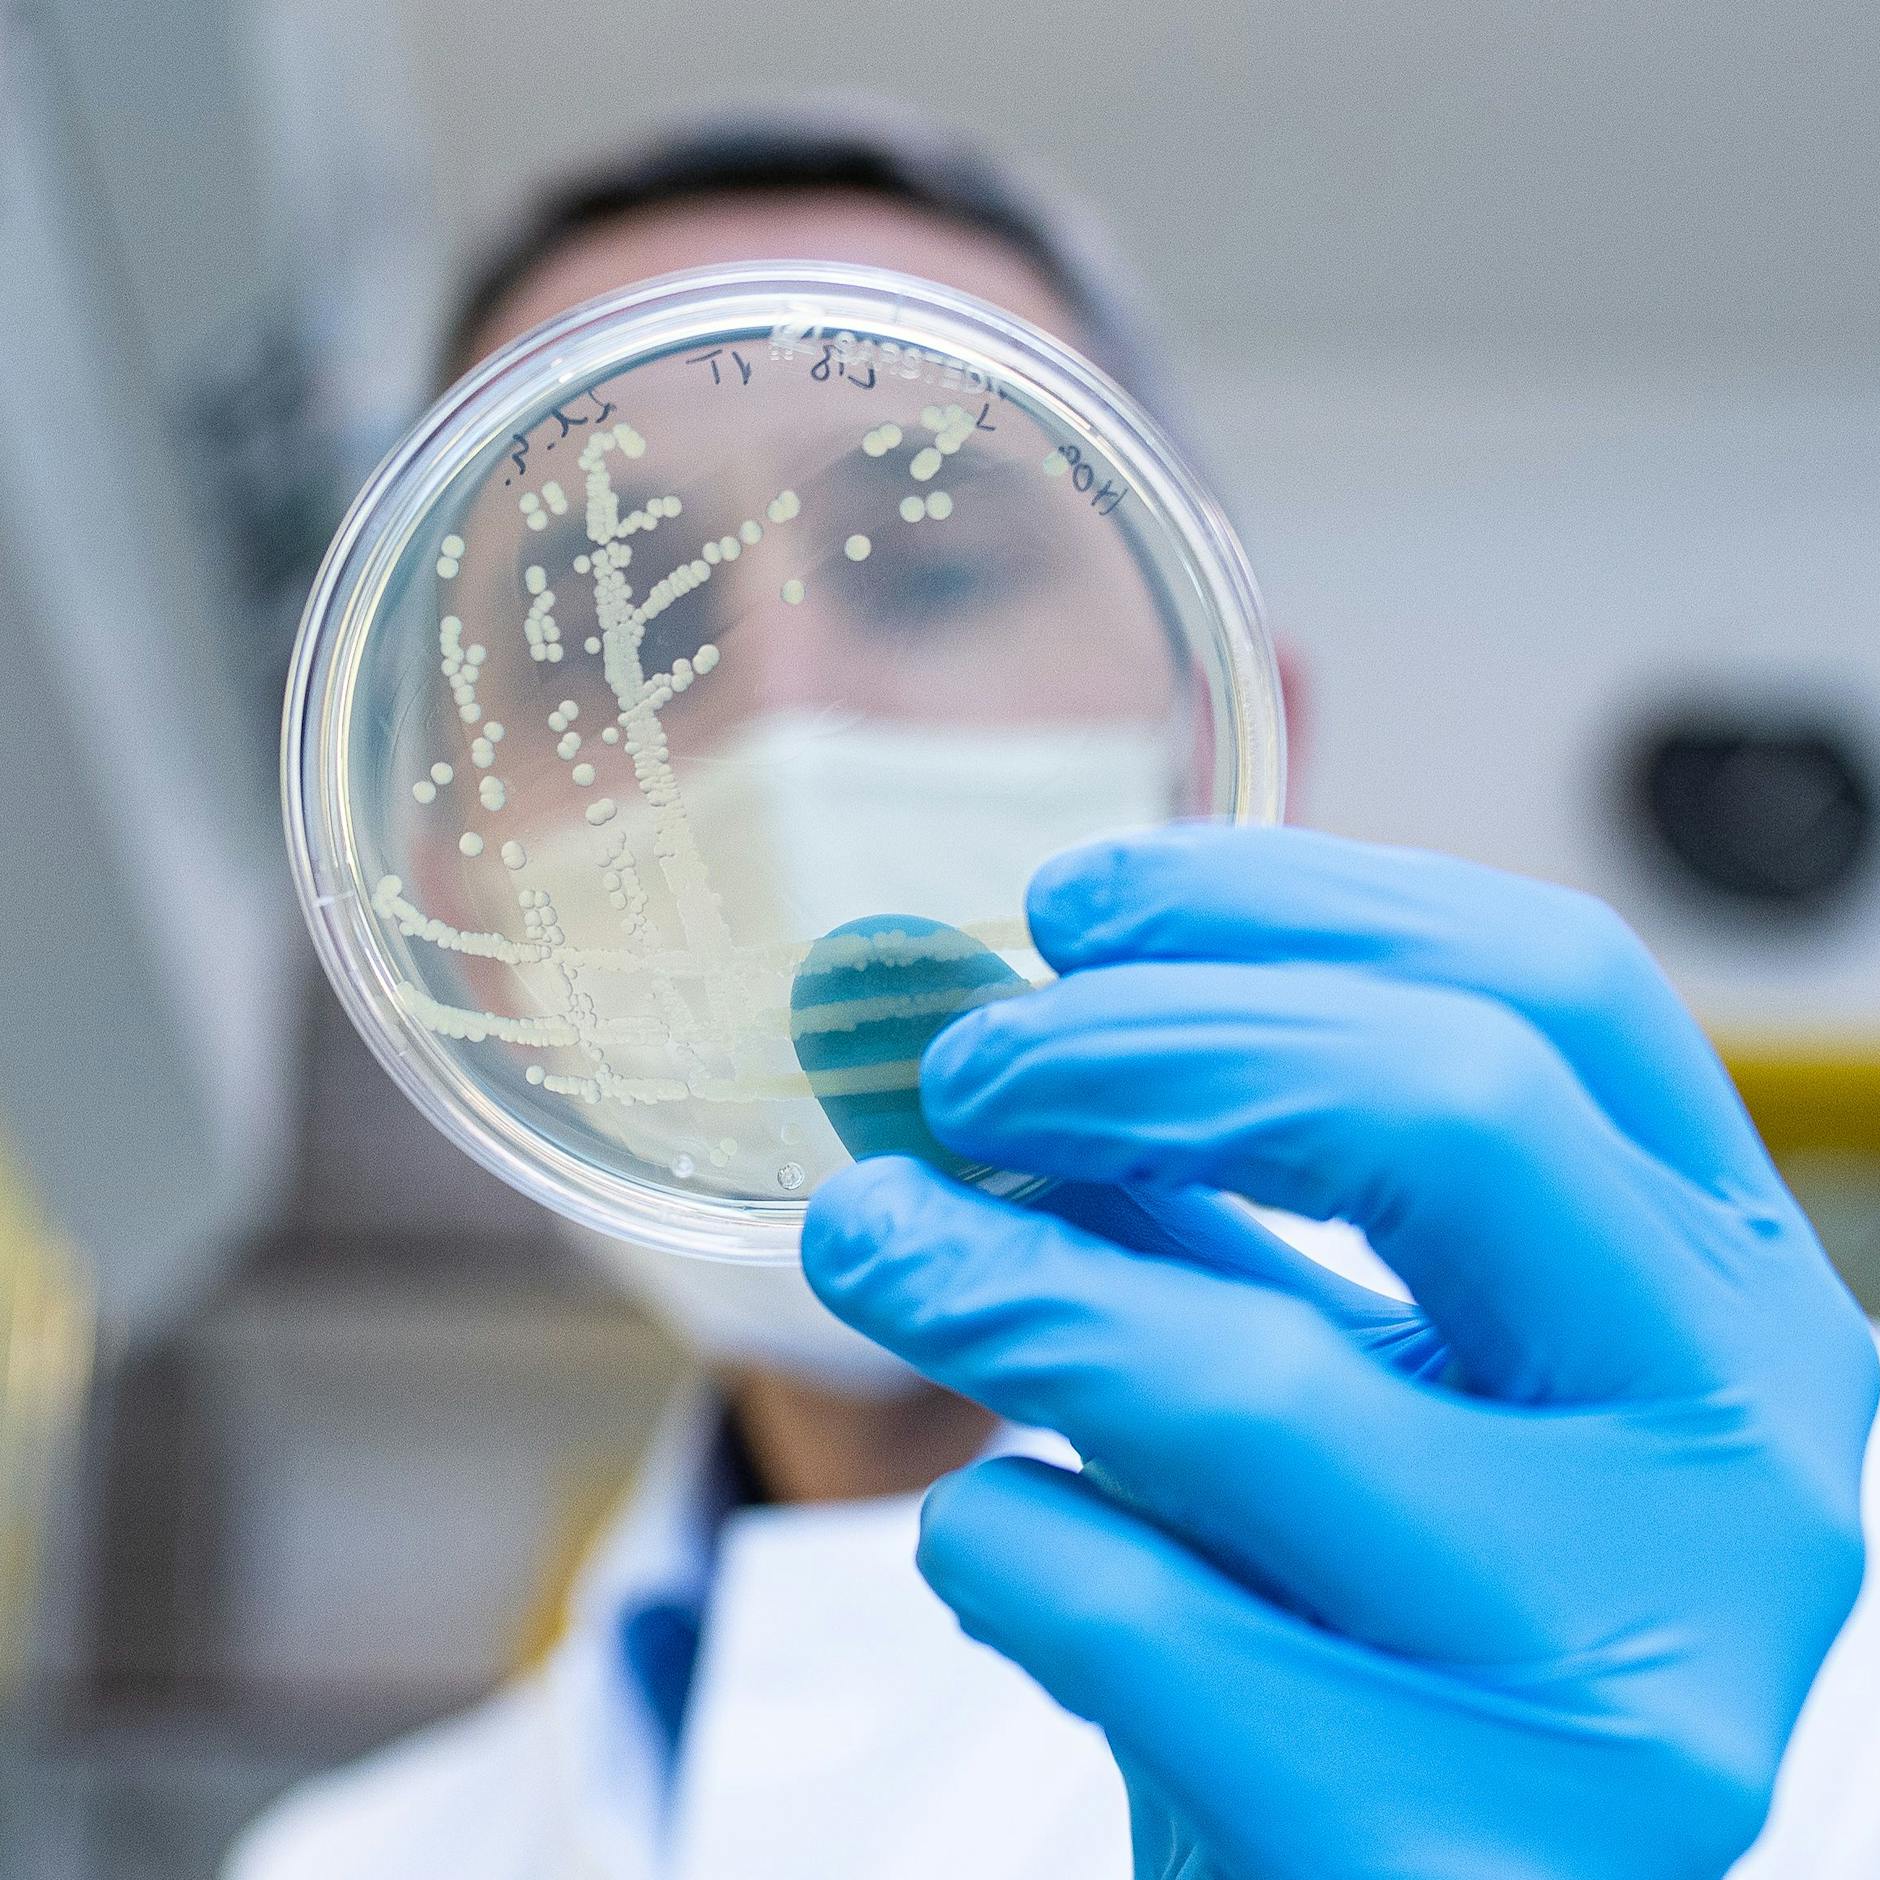
Ehec-Ausbruch in den Ferien: Schon sechs Berliner Kinder infiziert

Die Menschen in Berlin sind viel gewöhnt – und auch die Polizei hat hier immer wieder mit den absurdesten Fällen zu tun. Doch in den letzten 24 Stunden ereigneten sich in der Hauptstadt gleich zwei echte Horror-Taten, die fassungslos machen – und die vielen Angst bereiten dürften: In Wittenau wurde ein Autofahrer auf besonders heftige Art und Weise ausgeraubt, in einem U-Bahnhof schoss ein bisher unbekannter Täter mit einer Waffe gegen einen fahrenden Zug. Die unglaublichen Fälle.
Krasser Überfall: Trio drängt 26-jährigen im Auto ab – und raubt ihn aus!
Schon am Donnerstagabend kam es in Wittenau (Bezirk Reinickendorf) zur ersten Tat, die fassungslos macht – hier wurde ein Autofahrer von bisher unbekannten Tätern ausgeraubt. Deren Vorgehen hört sich an wie in einem Actionfilm: Der Fahrer des Autos (26) war mit seinem Wagen in der Gorkistraße unterwegs, als plötzlich ein anderes Auto auftauchte und ihn abdrängte. Die Fahrer des Fahrzeugs nötigten ihn zum Anhalten, teilte die Berliner Polizei mit.

Hinter ihm hielt kurz darauf ein weiteres Auto. Insgesamt drei Täter stiegen aus, bedrohten den Mann mit einer Schusswaffe. Außerdem schlugen sie ihr Opfer. Dann nahmen die bisher unbekannten Räuber ihm Wertsachen und Bargeld ab, stiegen wieder in ihre Autos und flohen. Laut Polizei Berlin klagte der 26-Jährige danach gegen Schmerzen im Rücken, blieb aber ansonsten unverletzt und musste auch nicht behandelt werden.